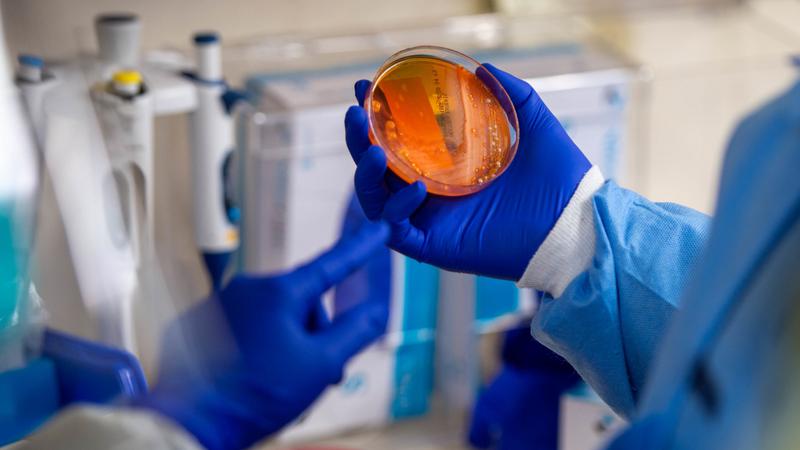

Author Archives:

Ukraine's leader warns war will cost Russia for generations
Ukrainian President Volodymyr Zelenskyy said Russian forces are blockading his country's largest cities to wear the population down into submission, but he warned Saturday that the strategy will fail ...
Mar 19, 2022

Thompson scores in OT as Sabres beat Flames 1-0
CALGARY - Tage Thompson scored the overtime winner and Dustin Tokarski made 24 saves as the Buffalo Sabres won 1-0 Friday night over the Calgary Flames. Buffalo (21-33-8) has split the first two games...
Mar 18, 2022

China reports first COVID-19 deaths in more than a year
BEIJING (AP) - China's national health authorities reported two COVID-19 deaths on Saturday, the first recorded rise in the death toll since January 2021, as the country battles an omicron-driven surg...
Mar 18, 2022

Hall scores in third to lift Bruins to a 4-2 victory over Winnipeg Jets
WINNIPEG - Taylor Hall scored a power-play goal with 4:47 left in the third period to help lift the Boston Bruins to a 4-2 victory over the Winnipeg Jets on Friday. Hall took advantage of a bouncing p...
Mar 18, 2022

Rep. Don Young, longtime Alaska congressman, dies at 88
JUNEAU, Alaska (AP) - Don Young, a blunt-speaking Republican who was the longest-serving current member of Congress, has died. He was 88. His office announced Young's death in a statement Friday night...
Mar 18, 2022

Norris scores the winner, Senators beat Flyers 3-1
OTTAWA - Josh Norris scored the winning goal midway through the third period Friday as the Ottawa Senators defeated the Philadelphia Flyers 3-1 and snapped a three-game losing streak. A slapshot from ...
Mar 18, 2022

Canada's Adam Hadwin second after two rounds of Valspar Championship
PALM HARBOR, Fla. (AP) - Two days around the Copperhead course has created very little stress for Canada's Adam Hadwin, with his game and between the ears. The 34-year-old from Abbotsford, B.C., has b...
Mar 18, 2022

199 new COVID-19 cases in B.C. as hospitalizations drop
VICTORIA - The provincial Health Ministry says there have been six more deaths related to COVID-19 in British Columbia as of Friday. It brings the death toll to 2,966 since the pandemic began. B.C. re...
Mar 18, 2022

Referendum recommended for future of Shuswap communities
It looks like residents of two Shuswap communities will get a chance to decide if they want to become one municipality.The Columbia Shuswap Regional District (CSRD) board of directors is recommending ...
Mar 18, 2022
COVID-19 cases and hospitalizations continue to fall
COVID-19 case numbers for British Columbia continued to decline on Friday, with 199 reported around the province, a decrease of 41 from Thursday.Of that total, Interior Health led the five health regi...
Mar 18, 2022

What Matters
Beaver Lake and Vernon Creek Watershed Improvements
Lake Country taking action to support water management, flows at area watershed
14h ago

Sponsored Content
Back-to-Back awards
Object On Wires
Power restored for over 3,600 properties
16h ago
Collision on 32nd St/HWY 97
Two people injured in Tuesday night crash
20h ago

Sponsored Content
What's up with your RV?
Crash into Shuswap River
Trial for helicopter crash case to go in 2027
Apr 21, 2026
First-Degree Murder
Pair charged in 2016 West Kelowna murder
Apr 20, 2026